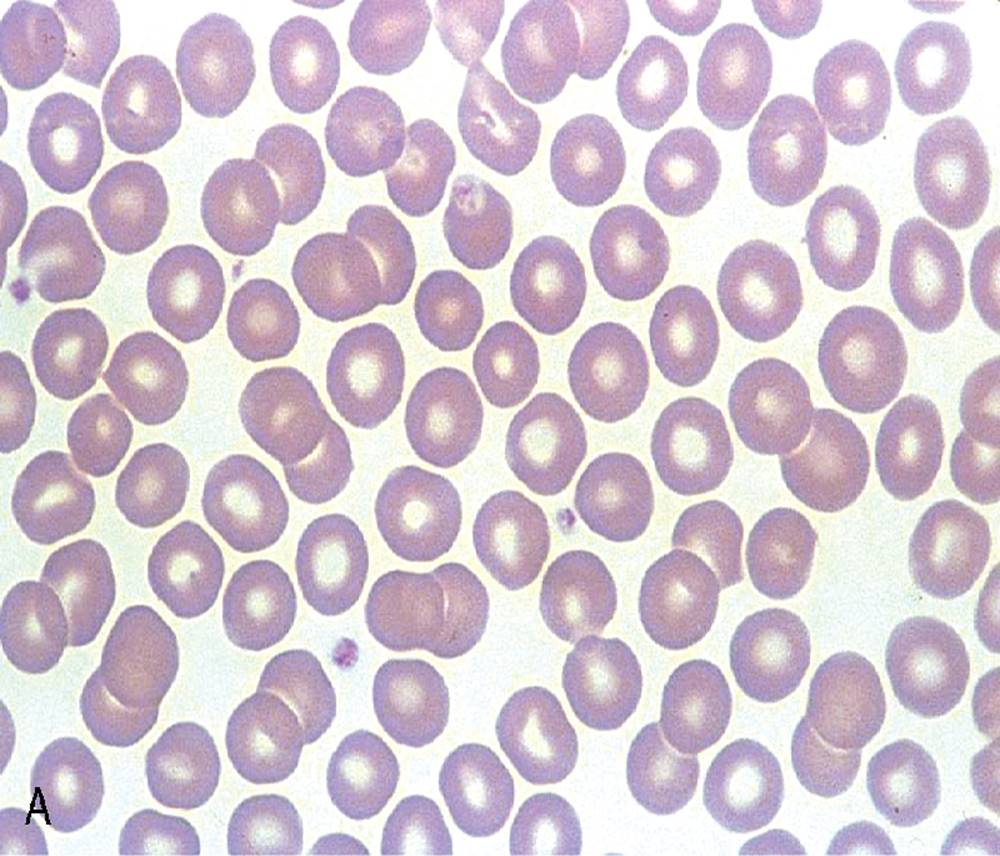
Image

Lynn B. Maedel, Kathryn Doig
OUTLINE
Peripheral Blood Films
Specimen Collection
Peripheral Film Preparation
Staining of Peripheral Blood Films
Peripheral Film Examination
Summarizing Complete Blood Count Results
Organization of Complete Blood Count Results
Assessing Hematology Results Relative to Reference Intervals
Summarizing White Blood Cell Parameters
Summarizing Red Blood Cell Parameters
Summarizing Platelet Parameters
Objectives
After completion of this chapter, the reader will be able to:
1. List the specimen sources and collection processes that are acceptable for blood film preparation.
2. Describe the techniques for making peripheral blood films.
3. Describe the appearance of a well-prepared peripheral blood film, recognize a description of a slide that is consistent or inconsistent with that appearance, and troubleshoot problems with poorly prepared films.
4. Explain the principle, purpose, and basic method of Wright staining of blood films.
5. Identify and troubleshoot problems that cause poorly stained blood films.
6. Describe the proper examination of a peripheral blood film, including selection of the correct area, sequence of examination, and observations to be made at each magnification. Recognize deviations from this protocol.
7. Given the number of cells observed per field and the magnification of the objective, apply formulas to estimate white blood cell (WBC) counts and platelet counts.
8. Explain the effect that platelet satellitosis and clumping may have on automated complete blood count (CBC) results. Recognize examples of results that would be consistent with these effects.
9. Follow the appropriate course of action to recognize and correct ethylenediaminetetraacetic acid–induced pseudothrombocytopenia and pseudoleukocytosis.
10. Implement a systematic approach to interpretation of CBC data that results in a verbal summary of the numerical data and communicates the blood picture succinctly.
11. Calculate absolute WBC differential counts.
Examination of the peripheral blood film and correlation with the complete blood count
CASE STUDY
After studying the material in this chapter, the reader should be able to respond to the following case study:
A healthy-looking 56-year-old man had an automated CBC performed as part of a preoperative evaluation. Results are shown here. Refer to reference intervals provided on the inside front cover of this book.
WBC—15.8 × 109/L
RBC—4.93 × 1012/L
HGB—14.8 g/dL
HCT—45.1%
MCV—91.5 fL
MCH—30 pg
MCHC—32.8 g/dL
RDW—14.2%
PLT—34 × 109/L
MPV—6.6 fL
The peripheral blood film was examined, and the only abnormal finding was “platelets in clumps.”
1. Describe the blood picture succinctly, using proper terminology for red blood cells, white blood cells, and platelets.
2. What automated results should be questioned?
3. What is the best course of action to handle this problem?
A well-made, well-stained, and carefully examined peripheral blood film can provide valuable information regarding a patient’s health. More can be learned from this test than from many other routinely performed hematologic tests. White blood cell (WBC) and platelet count estimates can be achieved, relative proportions of the different types of WBCs can be obtained, and the morphology of all three cell lines can be evaluated for abnormalities. Although routine work is now handled by the sophisticated automated instruments found in most hematology laboratories, skilled and talented laboratory professionals are still essential to the reporting of reliable test results. Accurate peripheral film evaluation is quite likely to be needed for some time.
The peripheral film evaluation is the capstone of a panel of tests called the complete blood count (CBC) or hemogram. The CBC includes enumeration of cellular elements, quantitation of hemoglobin, and statistical analyses that provide a snapshot of cell appearances. These results can be derived using the manual methods and calculations described in Chapter 14 or using the automated instruments described in Chapter 15. Regardless of method, the numerical values should be consistent with the assessment derived by examining the cells microscopically. Careful examination of the data in a systematic way ensures that all relevant results are noted and taken into consideration in the diagnosis.
This chapter begins with a discussion of the preparation and assessment of the blood film, followed by a systematic approach to review of the CBC, including blood film evaluation. Such an evaluation can be applied in the hematology chapters that follow.
Peripheral blood films
Specimen collection
Sources of specimens
Essentially all specimens received for routine testing in the hematology section of the laboratory have been collected in lavender (purple)–topped tubes (Chapter 3). These tubes contain disodium or tripotassium ethylenediaminetetraacetic acid (EDTA), which anticoagulates the blood by chelating the calcium that is essential for coagulation. Liquid tripotassium EDTA is often preferred to the powdered form because it mixes more easily with blood. High-quality blood films can be made from the blood in the EDTA tube, provided that they are made within 2 to 3 hours of drawing the specimen.1 Blood films from EDTA tubes that remain at room temperature for more than 5 hours often have unacceptable blood cell artifacts (echinocytic red blood cells [RBCs], spherocytes, necrobiotic leukocytes, and vacuolated neutrophils). Vacuolization of monocytes normally occurs almost immediately with EDTA but causes no evaluation problems.
The main advantages of making films from blood in the EDTA tube are that multiple slides can be made if necessary and they do not have to be prepared immediately after the blood is drawn. In addition, EDTA generally prevents platelets from clumping on the glass slide, which makes the platelet estimate more accurate during film evaluation. There are purists, however, who believe that anticoagulant-free blood is still the specimen of choice for evaluation of blood cell morphology.2 Although some artifacts can be avoided in this way, samples made from unanticoagulated blood pose other problems.
Under certain conditions, use of a different anticoagulant or no anticoagulant may be helpful. Some patients’ blood undergoes an in vitro phenomenon called platelet satellitosis3 when anticoagulated with EDTA. The platelets surround or adhere to neutrophils, which potentially causes pseudothrombocytopenia when counting is done by automated methods (Figure 16-1).3, 4 In addition, spuriously low platelet counts and falsely increased WBC counts (pseudoleukocytosis) can result from EDTA-induced platelet clumping.5 Pseudoleukocytosis occurs when platelet agglutinates are similar in size to WBCs and automated analyzers cannot distinguish the two. The platelet clumps are counted as WBCs instead of platelets. Platelet-specific autoantibodies that react best at room temperature are one of the mechanisms known to cause this phenomenon.6 In these circumstances, the examination of a blood film becomes an important quality control strategy, identifying these phenomena so that they can be corrected before the results are reported to the patient’s chart or health care provider.

FIGURE 16-1 Photomicrograph of platelet satellitosis.
Problems such as these can be eliminated by recollecting specimens in sodium citrate tubes (light blue top) and ensuring that the proper ratio of nine parts blood to one part anticoagulant is observed (a properly filled tube). These new specimens can be analyzed in the usual way by automated instruments. Platelet counts and WBC counts from sodium citrate specimens must be corrected for the dilution of blood with the anticoagulant, however. In a full-draw tube, the blood is nine tenths of the total tube volume (2.7 mL of blood and 0.3 mL of sodium citrate). The “dilution factor” is the reciprocal of the dilution (i.e., 10/9 or 1.1). The WBC and platelet counts are multiplied by 1.1 to obtain accurate counts. All other CBC parameters should be reported from the original EDTA tube specimen and slide.
Another source of blood for films is from finger and heel punctures. In general, the films are made immediately at the patient’s side. There are, however, a few limitations to this procedure. First, some platelet clumping must be expected if films are made directly from a drop of finger-stick or heel-stick blood or if blood is collected in heparinized microhematocrit tubes. Generally, this clumping is not enough to interfere with platelet estimates if the films are made promptly before clotting begins in earnest. Second, only a few films can be made directly from blood from a skin puncture before the site stops bleeding. If slides are made quickly and correctly, however, cell distribution and morphology should be adequate. These problems with finger and heel sticks can be eliminated with the use of EDTA microcollection tubes, such as Microtainer® Tubes (Becton, Dickinson and Company, Franklin Lakes, NJ) (Chapter 3).
Peripheral film preparation
Types of films
Manual wedge technique.
The wedge film technique is probably the easiest to master. It is the most convenient and commonly used method for making peripheral blood films. This technique requires at least two 3-inch × 1-inch (75-mm × 25-mm) clean glass slides. High-quality, beveled-edge microscopic slides with chamfered (beveled) corners for good lateral borders are recommended. A few more slides may be kept handy in case a good-quality film is not made immediately. One slide serves as the film slide, and the other is the pusher or spreader slide. They can then be reversed. It is also possible to make good wedge films by using a hemacytometer coverslip attached to a handle (pinch clip or tongue depressor) as the spreader.
A drop of blood (about 2 to 3 mm in diameter) from a finger, heel, or microhematocrit tube (nonheparinized for EDTA-anticoagulated blood or heparinized for capillary blood) is placed at one end of the slide. The drop also may be delivered using a Diff-Safe dispenser (Alpha Scientific Corporation, Malvern, PA). The Diff-Safe dispenser is inserted through the rubber stopper of the EDTA tube, which eliminates the need to remove the stopper.7 The size of the drop of blood is important: too large a drop creates a long or thick film, and too small a drop often makes a short or thin blood film. The pusher slide, held securely in the dominant hand at about a 30- to 45-degree angle (Figure 16-2, A), is drawn back into the drop of blood, and the blood is allowed to spread across the width of the slide (Figure 16-2, B). It is then quickly and smoothly pushed forward to the end of the slide to create a wedge film (Figure 16-2, C). It is important that the whole drop be picked up and spread. Moving the pusher slide forward too slowly accentuates poor leukocyte distribution by pushing larger cells, such as monocytes and granulocytes, to the very end and sides of the film. Maintaining an even, gentle pressure on the slide is essential. It is also crucial to keep the same angle all the way to the end of the film. When the hematocrit is higher than normal (i.e., > 60%), as is found in patients with polycythemia or in newborns, the angle should be lowered (i.e., 25 degrees) so the film is not too short and thick. For extremely low hematocrits, the angle may need to be raised. If two or three films are made, the best one is chosen for staining, and the others are disposed of properly. Some laboratories require two good films and save one unstained in case another slide is required.

FIGURE 16-2 A-C, Wedge technique of making a peripheral blood film.
The procedure just described is for a push-type wedge preparation. It is called push because the spreader slide is pulled into the drop of blood, and the film is made by pushing the blood along the slide. The same procedure can be modified to produce a pulled film. In this procedure, the spreader slide is pushed into the drop of blood and pulled along the length of the slide to make the film. Although this method is much less commonly used, it also provides a satisfactory wedge preparation and may be easier for some individuals to perform. Other variations on the wedge technique include using the 3-inch side of the slide as the spreader slide or balancing the spreader slide on the fingers to avoid placing too much pressure on it. Learning to make consistently good blood films takes a lot of practice but can be accomplished if one is patient and persistent.
Features of a well-made wedge peripheral blood film
1. The film is two thirds to three fourths the length of the slide (Figure 16-3).
2. The film is finger shaped, very slightly rounded at the feather edge, not bullet shaped; this provides the widest area for examination.
3. The lateral edges of the film are visible.
4. The film is smooth without irregularities, holes, or streaks.
5. When the slide is held up to the light, the thin portion (feather edge) of the film has a “rainbow” appearance.
6. The whole drop of blood is picked up and spread.

FIGURE 16-3 Well-made peripheral blood film.
, Figure 16-4 A-H, shows unacceptable films.

FIGURE 16-4 Unacceptable peripheral blood films. Slide appearances associated with the most common errors are shown, but note that a combination of causes may be responsible for unacceptable films. A, Chipped or rough edge on spreader slide. B, Hesitation in forward motion of spreader slide. C, Spreader slide pushed too quickly. D, Drop of blood too small. E, Drop of blood not allowed to spread across the width of the slide. F, Dirt or grease on the slide; may also be due to elevated lipids in the blood specimen. G, Uneven pressure on the spreader slide. H, Time delay; drop of blood began to dry.
Automated slide making and staining.
The Sysmex SP-10 (Sysmex Corporation of America, Mundelein, IL) is an automated slide-making and -staining system (). After the instrument has performed a CBC for a specimen, a conveyor moves the racked tube to the SP-10, where the bar code is read. User-definable, onboard rules built into the system determine whether a slide is required. Criteria for a manual slide review are determined by each laboratory based on its patient population. Based on the hematocrit reading, the system adjusts the size of the drop of blood used and the angle and speed of the spreader slide in making a wedge preparation. After each blood film is prepared, the spreader slide is automatically cleaned and is ready for the next blood film to be made. Films can be produced approximately every 30 seconds. Patient identification information, such as name, number, and date for the specimen, is printed on the slide. The slide is dried, loaded into a cassette, and moved to the staining position. Based on the laboratory’s desired stain protocol, stain and then buffer and rinse are added at designated times. When staining is complete, the slide is moved to a dry position, then to a collection area where it can be picked up for microscopic evaluation. Films made off-line, such as bone marrow smears and cytospin preparations, may be stained using this system as well. Other blood analyzer manufacturers, such as Beckman Coulter (Brea, CA), also have automated slide making and staining instruments. Figure 16-5

FIGURE 16-5 Sysmex SP-10 (Sysmex America, Inc., Lincolnshire, IL) is an automated slide making and staining system.
Drying of films
Regardless of film preparation method, before staining, all blood films and bone marrow smears should be dried as quickly as possible to avoid drying artifact. In some laboratories, a small fan is used to facilitate drying. Blowing breath on a slide is counterproductive because the moisture in breath causes RBCs to become echinocytic (crenated) or to develop water artifact (also called drying artifact).
Staining of peripheral blood films
Pure Wright stain or a Wright-Giemsa stain (Romanowsky stain)8 is used for staining peripheral blood films and bone marrow smears. These are considered polychrome stains because they contain both eosin and methylene blue. Giemsa stains also contain methylene blue azure. The purpose of staining blood films is simply to make the cells more visible and to allow their morphology to be evaluated. Consistent day-to-day staining quality is essential.
Methanol in the stain fixes the cells to the slide. Actual staining of cells or cellular components does not occur until the buffer is added. The oxidized methylene blue and eosin form a thiazine-eosinate complex, which stains neutral components. Because staining reactions are pH dependent, the buffer that is added to the stain should be 0.05 M sodium phosphate (pH 6.4) or aged distilled water (distilled water placed in a glass bottle for at least 24 hours; pH 6.4 to 6.8). Free methylene blue is basic and stains acidic (and basophilic) cellular components, such as ribonucleic acid (RNA). Free eosin is acidic and stains basic (and eosinophilic) components, such as hemoglobin and eosinophilic granules. Neutrophils are so named because they have cytoplasmic granules that have a neutral pH and pick up some staining characteristics from both stains. The slides must be completely dry before staining or the thick part of the blood film may come off the slide in the staining process.
Water or drying artifact has long been a nuisance to hematology laboratories. It has several appearances. It can give a moth-eaten look to the RBCs, or it may appear as a heavily demarcated central pallor. It also may appear as refractive (shiny) blotches on the RBCs. Other times, it manifests simply as echinocytes (crenation) seen in the areas of the slide that dried most slowly.
Multiple factors contribute to this problem. Humidity in the air as the slide dries may add to the punched-out, moth-eaten, or echinocytic appearance of the RBCs. It is difficult to avoid drying artifact on films from extremely anemic patients because of the very high ratio of plasma to RBCs. Water absorbed from the air into the alcohol-based stain also can contribute. Drying the slide as quickly as possible helps, and keeping a stopper tightly on the stain bottle keeps moisture out. In some laboratories, slides are fixed in pure, anhydrous methanol before staining to help reduce water artifact. More recently, stain manufacturers have used 10% volume-to-volume methanol to minimize water or drying artifact.
Wright staining methods
Manual technique.
Traditionally, Wright staining has been performed over a sink or pan with a staining rack. Slides are placed on the rack, film side facing upward. The Wright stain may be filtered before use or poured directly from the bottle through a filter onto the slide. It is important to flood the slide completely. The stain should remain on the slide at least 1 to 3 minutes to fix the cells to the glass. Then an approximately equal amount of buffer is added to the slide. Surface tension allows very little of the buffer to run off. A metallic sheen (or green “scum”) should appear on the slide if mixing is correct (). More buffer can be added if necessary. The mixture is allowed to remain on the slide for 3 minutes or more (bone marrow smears take longer to stain than peripheral blood films). The timing may be adjusted to produce the best staining characteristics. When staining is complete, the slide is rinsed with a steady but gentle stream of neutral-pH water, the back of the slide is wiped to remove any stain residue, and the slide is air-dried in a vertical position. Figure 16-6

FIGURE 16-6 Manual Wright staining of slides. Note metallic sheen of stain indicating proper mixing.
Use of the manual Wright staining technique is desirable for staining peripheral blood films containing very high WBC counts, such as the films from leukemic patients. As with bone marrow smears, the time can be easily lengthened to enhance the staining required by the increased numbers of cells. Understaining is common when a leukemia slide is placed on an automated slide stainer. The main disadvantages of the manual technique are the increased risk of spilling the stain and the longer time required to complete the procedure. This technique is best suited for low-volume laboratories.
Automated slide stainers.
Numerous automated slide stainers are commercially available. For high-volume laboratories, these instruments are essential. Once they are set up and loaded with slides, staining proceeds without operator attention. In general, it takes about 5 to 10 minutes to stain a batch of slides. The processes of fixing/staining and buffering are similar in practice to those of the manual method. The slides may be automatically dipped in stain and then in buffer and a series of rinses (Midas III, EM Science, Gibbstown, NJ) () or propelled along a platen surface by two conveyor spirals (Hema-Tek, Siemens Healthcare Diagnostics, Inc., Deerfield, IL) (Figure 16-7Figure 16-8). In the Hema-Tek device, stain, buffer, and rinse are pumped through holes in the platen surface, flooding the slide at the appropriate time. Film quality and color consistency are usually good with any of these instruments. Some commercially prepared stain, buffer, and rinse packages do vary from lot to lot or manufacturer to manufacturer, so testing is recommended. Some disadvantages of the dip-type batch stainers are (1) stat slides cannot be added to the batch once the staining process has begun, and (2) working or aqueous solutions of stain are stable for only 3 to 6 hours and need to be made often. Stat slides can be added at any time to the Hema-Tek stainer, and stain packages are stable for about 6 months.

FIGURE 16-7 Midas III slide stainer. Source: (Courtesy EM Science, Gibbstown, NJ.)

FIGURE 16-8 Hematek 3000 slide stainer. Source: (© 2014 Siemens Healthcare Diagnostics, Inc. Photo courtesy Siemens Healthcare Diagnostics.)
Quick stains.
Quick stains, as the name implies, are fast and easy. The whole process takes about 1 minute. The stain is purchased in a bottle as a modified Wright or Wright-Giemsa stain. The required quantity can be filtered into a Coplin jar or a staining dish, depending on the quantity of slides to be stained. Aged, distilled water is used as the buffer. Stained slides are given a final rinse under a gentle stream of tap water and allowed to air-dry. It is helpful to wipe off the back of the slide with alcohol to remove any excess stain. Quick stains are convenient and cost effective for low-volume laboratories, such as clinics and physician office laboratories, or whenever rapid turnaround time is essential. Quality is often a concern with quick stains. With a little time and patience in adjusting the staining and buffering times, however, color quality can be acceptable.
Features of a well-stained peripheral blood film.
Properly staining a peripheral blood film is just as important as making a good film. Macroscopically, a well-stained blood film should be pink to purple. Microscopically, the RBCs should appear orange to salmon pink, and WBC nuclei should be purple to blue. The cytoplasm of neutrophils should be pink to tan with violet or lilac granules. Eosinophils should have bright orange refractile granules. Faulty staining can be troublesome for reading the films, causing problems ranging from minor shifts in color to the inability to identify cells and assess morphology. Trying to interpret a poorly prepared or poorly stained blood film is extremely frustrating. If possible, a newly stained film should be studied. Hints for troubleshooting poorly stained blood films are provided in . Box 16-1
BOX 16-1
Troubleshooting Poorly Stained Blood Films
First scenario
Problems
RBCs appear gray.
WBCs are too dark.
Eosinophil granules are gray, not orange.
Causes
Stain or buffer too alkaline (most common)
Inadequate rinsing
Prolonged staining
Heparinized blood sample
Second scenario
Problems
RBCs are too pale or are red.
WBCs are barely visible.
Causes
Stain or buffer too acidic (most common)
Underbuffering (too short)
Over-rinsing
RBC, Red blood cell; WBC, white blood cell.
The best staining results are obtained on fresh slides because the blood itself acts as a buffer in the staining process. Slides stained after 1 week or longer turn out too blue. In addition, specimens that have increased levels of proteins (i.e., globulins) produce bluer-staining blood films, even when freshly stained.
Peripheral film examination
Microscopic blood film review is essential whenever instrument analysis indicates that specimen abnormalities exist. The laboratory professional evaluates the platelet and WBC count and differential, along with WBC, RBC, and platelet morphology.
Macroscopic examination
Examining the film before placing it on the microscope stage sometimes can give the evaluator an indication of abnormalities or test results that need rechecking. For example, a film that is bluer overall than normal may indicate that the patient has increased blood proteins, as in plasma cell myeloma, and that rouleaux may be seen on the film. A grainy appearance to the film may indicate RBC agglutination, as found in cold hemagglutinin diseases. In addition, holes all over the film could mean that the patient has increased lipid levels, and some of the automated CBC parameters should be rechecked for interferences from lipemia. Markedly increased WBC counts and platelet counts can be detected from the blue specks out at the feather edge. Valuable information might be obtained before the evaluator looks through the microscope.
Microscopic examination
The microscope should be adjusted correctly for blood film evaluation. The light from the illuminator should be properly centered, the condenser should be almost all the way up and adjusted correctly for the magnification used, and the iris diaphragm should be opened to allow a comfortable amount of light to the eye. Many individuals prefer to use a neutral density filter over the illuminator to create a whiter light from a tungsten light source. If the microscope has been adjusted for Koehler illumination, all these conditions should have been met (Chapter 4).
10× objective examination.
Blood film evaluation begins using the 10× or low-power objective lens (total magnification = 100×). Not much time needs to be spent at this magnification. However, it is a common error to omit this step altogether and go directly to the higher-power oil immersion lens. At the low-power magnification, overall film quality, color, and distribution of cells can be assessed. The feather edge and lateral edges should be checked quickly for WBC distribution. The presence of more than four times the number of cells per field at the edges or feather compared with the monolayer area of the film indicates that the film is unacceptable (i.e., a “snowplow” effect), and the film should be remade. Under the 10× objective, it is possible to check for the presence of fibrin strands; if they are present, the sample should be rejected, and another one should be collected. RBC distribution can be noted as well. Rouleaux formation or RBC agglutination is easy to recognize at this power. The film can be scanned quickly for any large abnormal cells, such as blasts, reactive lymphocytes, or even unexpected parasites. Finally, the area available for suitable examination can be assessed.
40× high-dry or 50× oil immersion objective examination.
The next step is using the 40× high-dry objective lens (total magnification = 400×) or, as many laboratories now use, a 50× oil immersion objective instead. At either of these magnifications, it is easy to select the correct area of the film in which to begin the differential count and to evaluate cellular morphology. The WBC estimate also can be performed at these powers. To perform a WBC estimate, the evaluator selects an area in which the RBCs are separated from one another with minimal overlapping (where only two or three RBCs can overlap). Depending on which lens is used (40× or 50×), the procedure is the same; only the multiplication factor changes. Count the WBCs in 10 fields and find the average number of WBCs/field. The average number of WBCs per high-power field (40×) is multiplied by 2000 (if a 50× oil lens is used, multiply by 3000) to get an approximation of the WBC count per μL of blood. For example, when using a 50× oil objective, if after 10 fields are scanned it is determined that there are four to five WBCs per field, this would yield a WBC estimate of 12, 000 to 15, 000/μL or mm3 (12 to 15 × 109/L). Box 16-2 contains a summary of the procedure for the WBC count estimate. This technique can be helpful for internal quality control, although there are inherent errors in the process. Using an area of the film that is too thick (toward the origin of the film) or too thin (toward the feather edge) affects the estimates. In addition, field diameters may vary among microscope manufacturers and models, so validation of the estimation multiplication factor should be performed first (Box 16-3). Checking for a discrepancy between the estimate and the instrument WBC count makes it easier to discover problems such as a film made using the wrong patient’s blood sample or a mislabeled film. In many laboratories, WBC estimates are performed on a routine basis; in others, these estimates are performed only as needed to confirm instrument values.
BOX 16-2
Performing a White Blood Cell Estimate
1. Select an area of the blood film in which most RBCs are separated from one another with minimal overlapping of RBCs.
2. Using the 40× high-dry or 50× oil immersion objective, count the number of WBCs in 10 consecutive fields, and calculate the average number of WBCs per field.
3. To obtain the WBC estimate per μL of blood, multiply the average number of WBCs per field by 2000* (if using the 40× high-dry objective) or 3000* (if using the 50× oil immersion objective).
4. Compare the instrument WBC count with the WBC estimate from the blood film.
Example: If an average of three WBCs were observed per field:
Using a 40× high-dry objective, the WBC estimate is 6000/μL or mm3 or 6.0 × 109/L.
Using a 50× oil immersion objective, the WBC estimate is 9000/μL or mm3 or 9.0 × 109/L.
* WBC estimation factors of 2000 (40× objective) and 3000 (50× objective) are provided as general guidelines. A WBC estimation factor should be determined and validated for each microscope in use (Box 16-3).
BOX 16-3
Validation of the White Blood Cell and Platelet Estimation Factor
1. Perform automated white blood cell (WBC) and platelet (PLT) counts on 30 consecutive fresh patient blood specimens. Make sure the counts are in control.
2. Prepare and stain one peripheral blood film for each specimen.
3. Using the 40× high-dry or 50× oil immersion objective for the WBC estimate and the 100× oil immersion objective for the PLT estimate, select an area of the blood film in which most RBCs are separated from one another with minimal overlapping of RBCs.
4. Count the number of WBCs or PLTs in 10 consecutive fields using the magnification specified in step 3, and calculate the average number of WBCs and PLTs per field.
5. For each of the 30 specimens, divide the automated WBC count by the average number of WBCs per field (40× or 50×); divide the automated PLT count by the average number of PLTs per field (100×).
6. Add the numbers obtained in step 5 for the WBCs, and divide by 30 (the number of observations in this analysis) to obtain the average ratio of the WBC count-to-WBCs per 40× or 50× field; add the numbers obtained in step 5 for the PLTs, and divide by 30 (the number of observations in this analysis) to obtain the average ratio of the PLT count-to-PLTs per 100× field.
7. Round the number calculated in step 6 to the nearest whole number to obtain an estimation factor for WBCs and PLTs at the specified magnification.
NOTE: Because of the variation in the field diameter among different microscopes, an estimation factor should be determined for each microscope in use, and that number should be used to obtain the WBC and PLT estimates when using that microscope.
Modified from Terrell JC: Laboratory evaluation of leukocytes. In Stiene-Martin EA, Lotspeich-Steininger CA, Koepke JA, editors: Clinical hematology—principles, procedures, correlations, ed 2, Philadelphia, 1998, Lippincott-Raven Publishers, p. 337.
100× oil immersion objective examination.
The 100× oil immersion objective provides the highest magnification on most standard binocular microscopes (10× eyepiece × 100× objective lens = 1000× magnification). The WBC differential count generally is performed using the 100× oil immersion objective. Performing the differential normally includes counting and classifying 100 WBCs to obtain percentages of WBC types. The RBC, WBC, and platelet morphology evaluation and the platelet estimate also are executed under the 100× oil immersion objective lens. At this magnification segmented neutrophils can be readily differentiated from bands. RBC inclusions, such as Howell-Jolly bodies, and WBC inclusions, such as Döhle bodies, can be seen easily if present. Reactive or abnormal cells are enumerated under the 100× objective as well. If present, nucleated RBCs (NRBCs) are counted and reported as NRBCs per 100 WBCs (Chapter 14).
50× oil immersion objective examination.
The WBC differential and morphology examinations described for the 100× oil immersion objective also can be accomplished by experienced morphologists using a 50× oil immersion objective. The larger field of view allows more cells to be evaluated faster. Examination at this power is especially efficient for validating or verifying instrument values when a total microscopic assessment of the film is not needed. Particular cell features that may require higher magnification can be assessed by moving the parfocal 100× objective into place and then returning to the 50× objective to continue the differential. As previously mentioned, the WBC estimate also can be performed with the 50× objective, but the multiplication factor is 3000. The observer should conform to the estimation protocol of the particular laboratory.
Optimal assessment area.
The tasks described, especially for the 100×, 40×, and 50× objectives, need to be performed in the best possible area of the peripheral blood film. That occurs between the thick area, or “heel, ” where the drop of blood was initially placed and spread, and the very thin feather edge. In the ideal area, microscopically, the RBCs are uniformly and singly distributed, with few touching or overlapping, and have their normal biconcave appearance (central pallor) (, Figure 16-9 A). An area that is too thin, in which there are holes in the film or the RBCs look flat, large, and distorted, is unacceptable (Figure 16-9, B). A too-thick area also distorts the RBCs by piling them on top of one another like rouleaux (Figure 16-9, C). WBCs are similarly distorted, which makes morphologic evaluation more difficult and classification potentially incorrect. When the correct area of a specimen from a patient with a normal RBC count is viewed, there are generally about 200 to 250 RBCs per 100× oil immersion field.

FIGURE 16-9 A, Photomicrograph of good area of peripheral blood film. Photomicrographs of peripheral blood film with areas too thin (B) and too thick (C) to read.
Although already discussed in Chapter 4, a common problem encountered with the oil immersion objective lens is worth mentioning again. If the blood film was in focus under the 10× and 40× objectives but is impossible to bring into focus under the 100× objective, the slide is probably upside down. The 100× objective does not have sufficient depth of field to focus through the slide. The oil must be completely removed before the film is put on the stage right-side up.
Performance of the white blood cell differential.
Fewer manual differentials are performed today because of the superior accuracy of automated differentials and because of cost and time constraints. When indicated, however, the manual differential always should be performed in a systematic manner. When the correct area has been selected, use of a back-and-forth serpentine, or “battlement, ” track pattern is preferred to minimize distribution errors ()Figure 16-109and ensure that each cell is counted only once. One hundred WBCs are counted and classified through the use of push-down button counters (Figure 16-11, A) or newer computer-interfaced key pads (Figure 16-11, B). To increase accuracy, it is advisable to count at least 200 cells when the WBC count is higher than 40 × 109/L. If the WBC count is 100 × 109/L or greater, it would be more precise and accurate to count 300 or 400 cells. Results are reported as percentages—for example, 54% segmented neutrophils, 6% bands, 28% lymphocytes, 9% monocytes, 3% eosinophils. The evaluator always should check to ensure that the sum of the percentages is 100.

FIGURE 16-10 “Battlement” pattern for performing a differential count.


FIGURE 16-11 A, Laboratory differential tally counter. B, Computer interfaced key pad counter.
Performing 100-cell differentials on extremely low WBC counts can become tedious and time consuming, even when the 50× oil immersion objective is used. In some laboratories, the WBCs are concentrated by centrifugation, and buffy coat smears are made. This practice is helpful for examining the morphology of the cells; however, it is not recommended for performing differentials because of possible errors in cell distribution from centrifugation. In other laboratories evaluators may perform a 50-cell differential and multiply the results by 2 to get a percentage. The accuracy of this practice is questionable, and it should be avoided if possible. In some laboratories the buffy coat smear is examined for the presence of blasts, but no differential is performed. It is essential to include the side margins of the blood film in any differential so that the larger cells, such as monocytes, reactive lymphocytes, and immature cells, are not missed.
In addition to counting the cells, the evaluator assesses their appearance. If present, WBC abnormalities such as toxic granulation, Döhle bodies, reactive lymphocytes, and Auer rods (Chapters 29 and 35) are evaluated and reported. Unfortunately, the exact method by which these are reported varies from laboratory to laboratory. Reactive lymphocytes may be reported as a separate percentage of the 100 cells, as a percentage of the total number of lymphocytes, or semiquantitatively (“occasional” to “many”). Toxic granulation generally is reported as “present” or is sometimes reported semiquantitatively (“slight” to “marked, ” or 1+ to 3+). Standardization of this process has been difficult, but laboratorians must look to simplify blood film morphology reports to help ensure better accuracy, consistency, and clinical relevance. Simply reporting “present” is becoming preferable to the older “semiquantitative” reporting of morphology abnormalities. Regardless of reporting format, each laboratory should establish criteria for reporting microscopic cell morphology.
Because the differential alone provides only partial information, reported in relative percentages, the absolute cell counts are calculated for each cell type in some laboratories. Automated differentials already include this information.
Automation has also been applied to the processes of microscopic cell location and identification. These automated systems are especially dependent on the quality and consistency of the blood film and stain in order for the digital systems to recognize and identify the cells. Once cells are located, a digital image is made and the cell is classified using sophisticated computerized visual recognition systems. Digital images of the classified cells are presented to the operator, who can override the instrument’s identification, if needed, or add identifications for cells that the instrument could not classify (). Figure 16-12

FIGURE 16-12 CellaVision DM96. CellaVision is an example of an automated system for differential counting that locates blood cells on a stained peripheral blood film, takes digital images, classifies the cells, and presents the cells in the 100-cell differential count to the operator on a computer screen. The operator can override the instrument’s classification and identify cells that the instrument could not classify. Source: (Courtesy of Cellavision AB, Lund, Sweden.)
Red blood cell morphology.
Evaluation of RBC morphology is an important part of the blood film examination and includes an assessment of cell size (microcytosis, macrocytosis), variability in size (anisocytosis), cell color (hypochromia), cell shape (poikilocytosis), and cellular inclusions (Chapter 19). Some laboratories use specific terminology for reporting the degree of abnormal morphology, such as “slight, ” “moderate, ” or “marked, ” or use a scale from 1+ to 3+. Other laboratories more recently have gone to a more simple report, using the term present for morphologic abnormalities that are clinically significant. Still other laboratories provide a summary statement regarding the overall RBC morphology that is consistent with the RBC indices and histogram. The latter methods are becoming more popular with the increased computer interfacing in most laboratories. Regardless of the reporting method used, the microscopic RBC morphology assessment should be congruent with the information given by the automated hematology analyzer. If not, further investigation is needed.
Platelet estimate.
As previously mentioned, the platelet estimate is performed under the 100× oil immersion objective lens. In an area of the film where the RBCs barely touch, with a few overlapping, the number of platelets in 10 oil immersion fields is counted. The average number of platelets per oil immersion field times 20, 000 approximates the platelet count per μL or mm3. For example, 12 to 16 platelets per oil immersion field equals about 280, 000 platelets/μL or mm3 (280 × 109/L) and is considered adequate. Box 16-4 contains a summary of the procedure for the platelet estimate. In situations in which the patient is anemic or has erythrocytosis, however, the relative proportion of platelets to RBCs is altered. In these instances, a more involved formula for platelet estimates may be used:

BOX 16-4
Performing a Platelet Estimate
1. Select an area of the blood film in which most RBCs are separated from one another with minimal overlapping of RBCs.
2. Using the 100× oil immersion objective, count the number of platelets in 10 consecutive fields, and calculate the average number of platelets per field.
3. To obtain the platelet estimate per μL of blood, multiply the average number of platelets per field by 20, 000*.
4. Compare the instrument platelet count with the platelet estimate from the blood film.
Example: If an average of 20 platelets were observed per 100× oil immersion field, the platelet estimate is 400, 000/μL or mm3 (400 × 109/L).
In instances of significant anemia or erythrocytosis, use the following formula for the platelet estimate:
*A platelet estimation factor of 20, 000 is provided as a general guideline. A platelet estimation factor should be determined and validated for each microscope in use (Box 16-3).
(200 is the average number of RBCs per oil immersion field in the optimal assessment area)
Regardless of whether or not an “official” estimate is made, verification of the instrument platelet count should be included in the overall examination for internal quality control purposes. Blood film examination also includes an assessment of the morphology of the platelets, including size as well as granularity and overall appearance.
As mentioned in Chapter 4, and worth mentioning again, immersion oils with different viscosities do not mix well. If slides are taken to another microscope for review, oil should be wiped off first.
Summarizing complete blood count
To this point, this chapter has focused on slide preparation and performance of a differential cell count. The differential is only the capstone, however, of a panel of tests collectively called the complete blood count, or CBC, that includes many of the routine tests described in Chapter 14. Now that the testing for the component parts has been described, interpretation of the results for the total panel can be discussed.
The CBC has evolved over time to the typical test panel reported today, including assessment of WBCs, RBCs, and platelets. The CBC provides information about the hematopoietic system, but because abnormalities of blood cells can be caused by diseases of other organ systems, the CBC also plays a role in screening of those organs for disease. The CBC provides such valuable information about a patient’s health status that it is among the most frequently ordered laboratory tests performed by medical laboratory scientists and laboratory technicians.
The process of interpreting the CBC test results has two phases. In phase 1, the numbers and descriptions generated by the testing are summarized using appropriate terminology. This summary provides a verbal picture of the numbers that is easy to communicate to the physician, other health care provider, or another laboratorian. It is much more convenient to be able to say, “The patient has a microcytic anemia” than to say, “The hemoglobin was low, and the mean cell volume was also low.” Phase 2 of interpretation is to recognize a pattern of results consistent with various diseases and to be able to narrow the diagnosis for the given patient or perhaps even to pinpoint it so that appropriate follow-up testing or treatment can be recommended.
The following discussion focuses on phase 1 of CBC interpretation—how to collect the pertinent information and summarize it. Phase 2 of the interpretation is the essence of the remaining chapters of this book on various hematologic conditions or other metabolic conditions that have an impact on the hematologic system.
Organization of complete blood count results
Today, most laboratorians perform CBCs using sophisticated automated analyzers as described in Chapter 15, but the component tests can be performed using the manual methods described in Chapter 14. The blood film assessment described in this chapter is also part of a CBC. As previously mentioned, the CBC “panel” is essentially divided into WBC, RBC, and platelet parameters.
For phase 2 interpretation, it is sometimes important to look at all three groupings of the CBC results; at other times, only one or two may be of interest. If a patient has an infection, the WBC parameters may be the only ones of interest. If the patient has anemia, all three sets—WBCs, RBCs, and platelets—may require assessment. Generally, all the parameters interpreted together provide the best information, so a complete summary of the results should be generated.
Assessing hematology results relative to reference intervals
Proper performance of the phase 1 summary of test results requires comparison of the patient values with the reference intervals. The table of reference intervals for the CBC on the inside cover of this text shows that there are different reference intervals for men and women, particularly for the RBC parameters. There also are different intervals for children of different ages, with the WBC changes the most notable. It is important to select the appropriate set of reference intervals in hematology for the gender and age of the patient.
CBC results can be reported in standard international (SI) units or in common units. For example the following results in SI units (WBC count = 7.2 × 109/L, RBC count = 4.20 × 1012/L, HGB = 128 g/L, HCT = 0.41 L/L, and PLT = 237 × 109/L) are equivalent to the following results in common units (WBC count = 7.2 × 103/μL, RBC count = 4.20 × 106/μL, HGB = 12.8 g/dL, HCT = 41%, and PLT = 237 × 103/μL). The older mm3 for cell count units is equivalent to μL (Chapter 14). Since either system may be used on laboratory reports, the laboratorian should be able to easily interconvert CBC results between the systems. SI units are used for the cell counts in this chapter.
Several strategies can help in determining the significance of the results. First, if the results are very far from the reference interval, it is more likely that they are truly outside the interval and represent a pathologic process. Second, if two or more diagnostically related parameters are slightly or moderately outside the interval in the same direction (both high or both low), this suggests that the results are clinically significant and associated with some pathologic process. Because some healthy individuals always have results slightly outside the reference interval, the best comparison for their results is not the reference interval but their own results from a prior time when they were known to be healthy.
Summarizing white blood cell parameters
The WBC-related parameters of a routine CBC include the following:
1. Total WBC count (WBCs × 109/L)
2. WBC differential count values expressed as percentages, called relative counts
3. WBC differential count values expressed as the actual number of each type of cell (e.g., neutrophils × 109/L), called absolute counts
4. WBC morphology
Step 1
Start by ensuring that there is an accurate WBC count. Compare the WBC histogram and/or scatterplot to the respective cell counts to make sure they correlate with one another. Today’s automated instruments are able to eliminate nucleated RBCs that falsely increase the WBC count. However, manual WBC results must be corrected mathematically to eliminate the contribution of the NRBCs (Chapter14).
Step 2
Look at the total WBC count. When the count is elevated, it is called leukocytosis. When the WBC count is low, it is called leukopenia. As described later, increases and decreases of WBCs are associated with infections and conditions such as leukemias. Because there is more than one type of WBC, increases and decreases in the total count are usually due to changes in one of the subtypes—for example, neutrophils or lymphocytes. Determining which one is the next step.
Step 3
Examine the relative differential counts for a preliminary assessment of which cell lines are affected. The relative differential count is reported in percentages. The proportion of each cell type can be described by its relative number (i.e., percent) and compared with its reference interval. Then it is described using appropriate terminology, such as a relative neutrophilia, which is an increase in neutrophils, or a relative lymphopenia, which is a decrease in lymphocytes. The terms used for increases and decreases of each cell type are provided in . Table 16-1
TABLE 16-1
Terminology for Increases and Decreases in White Blood Cells
|
Cell Type |
Increases |
Decreases |
|
Neutrophil |
Neutrophilia |
Neutropenia |
|
Eosinophil |
Eosinophilia |
N/A |
|
Basophil |
Basophilia |
N/A |
|
Lymphocyte |
Lymphocytosis |
Lymphopenia (lymphocytopenia) |
|
Monocyte |
Monocytosis |
Monocytopenia |
N/A, Not applicable because the reference interval begins at or near zero.
If the total WBC count or any of the relative values are outside the reference interval, further analysis of the WBC differential is needed. If the proportion of one of the cell types increases, then the proportion of others must decrease because the proportions are relative to one another. The second cell type may not have changed in actual number at all, however. The way to assess this accurately is with absolute differential counts.
Step 4
If not reported by the instrument, absolute counts can be calculated easily using the total WBC count and the relative differential. Multiply each relative cell count (i.e., percentage) by the total WBC count and by so doing determine the absolute count for each cell lineage.
Examine the set of WBC parameters from a CBC shown in . On first inspection, one may look at the WBC count and recognize that a leukocytosis is present, but it is important to determine what cell line is causing the increased count. In this case, the cells are all within reference intervals relative to one another. There is no indication as to which cell line could be causing the increase in total numbers of WBCs. Table 16-2
TABLE 16-2
Comparison of Relative and Absolute White Blood Cell Counts
|
Complete Blood Count Parameter |
Patient Value |
Reference Interval |
Interpretation Relative to Reference Interval |
Description/Summary |
|
White blood cell count |
13.6 |
4.3–10.8 × 109/L |
Elevated |
Leukocytosis |
|
Relative Differential |
||||
|
Neutrophils |
67 |
48%–70% |
WRI |
|
|
Lymphocytes |
26 |
18%–42% |
WRI |
|
|
Monocytes |
3 |
1%–10% |
WRI |
|
|
Eosinophils |
3 |
1%–4% |
WRI |
|
|
Basophils |
1 |
0%–2% |
WRI |
|
|
Absolute Differential |
||||
|
Absolute neutrophils |
9.1 |
2.4-8.2 × 109/L |
Elevated |
Absolute neutrophilia |
|
Absolute lymphocytes |
3.5 |
1.4-4 × 109/L |
WRI |
|
|
Absolute monocytes |
0.4 |
0.1-1.2 × 109/L |
WRI |
|
WRI, Within reference interval.
When each relative number (e.g., neutrophils at 0.67 or 67%) is multiplied by the total WBC count (13.6 × 109/L), the absolute numbers indicate that the neutrophils are elevated (9.1 × 109/L compared with the reference interval provided). The acronym for absolute neutrophil count is ANC. The ANC is a very useful parameter for assessing neutropenia and neutrophilia. The absolute lymphocyte count (3.5 × 109/L) is still within the reference interval. Given this information, these results can be described as showing a leukocytosis with only an absolute neutrophilia, and the overall increase in the WBC count is due to an increase only in neutrophils. This description provides a concise summary of the WBC counts without the need to refer to every type of cell. Box 16-5 extends this concept to a convention used to describe the neutrophilic cells, and Box 16-6 addresses the clinical utility of reporting % bands as a separate category.
BOX 16-5
Summarizing Neutrophilia When Young Cells Are Present
A subtle convention in assessing the differential counts has to do with the presence of young cells of the neutrophilic series (e.g., bands). They typically are grouped together with the mature neutrophils in judging whether neutrophilia is present. For example, look at the following differential and the reference intervals provided in parentheses:
White blood cells—10.8 × 109/L
Neutrophils (also called segmented neutrophils)—65 (48% to 70%)
Bands—18 (0% to 10%)
Lymphocytes—13 (18% to 42%)
Monocytes—3 (1% to 10%)
Eosinophils—1 (1% to 4%)
Basophils—0 (0% to 2%)
Although the mature neutrophils are within the reference interval, the bands exceed their reference interval. The total of the two, 83 (65% + 18%), exceeds the upper limit of neutrophilic cells even when the two intervals are combined, 80 (70% + 10%), so these results would be described as a neutrophilia even though the neutrophil value itself is within the reference interval. See steps 4 and 5 under Summarizing White Blood Cell Parameters for how to communicate the increase in bands.
BOX 16-6
Clinical Utility of Band Counts
An elevated band count was thought to be useful in the diagnosis of patients with infection. However, the clinical utility of band counts has been called into question, and most laboratories no longer perform routine band counts.11 The Clinical and Laboratory Standards Institute (CLSI) recommends that bands and neutrophils be counted together and placed in a single category rather than in separate categories because it is difficult to reliably differentiate bands from segmented neutrophils.12-14
When the absolute numbers of each of the individual cell types are totaled, the sum equals the WBC count (slight differences may occur due to rounding, as in the example). This is a method for checking whether the absolute calculations are correct. Absolute counts may be obtained directly from automated analyzers, which count actual numbers (i.e., produce absolute counts) and calculate relative values. Some laboratories do not report the absolute counts, so being able to calculate them is important.
As will be evident in later chapters, the findings in this particular example point toward a bacterial infection. Had there been an absolute lymphocytosis, a viral infection would be likely.
Step 5
Each cell line should be examined for immature cells. Young WBCs are not normally seen in the peripheral blood, and they may indicate infections or malignancies such as leukemia. For neutrophilic cells, there is a unique term that refers to the presence of increased numbers of bands or cells younger than bands in the peripheral blood: left shift or shift to the left (Box 16-7).
BOX 16-7
Origin of the Phrase Left Shift
The origin of the phrase left shift is a 1920s publication by Josef Arneth in which neutrophil maturity was correlated with segment count. A graphical representation was made, and the fewer the segments, the farther left was the median—hence left shift. This was called the Arneth count or Arneth-Schilling count and was abandoned around the time Arneth died in 1955, but the term left shift lived on to describe increased numbers of immature cells as an indicator of infection.
When young lymphocytic or monocytic cells are present, they can be reported in the differential as prolymphocytes, lymphoblasts, promonocytes, or monoblasts. When observed, young eosinophils and basophils are typically just called immature and are not specifically staged. For example, eosinophilic metamyelocytes are counted as eosinophils.
Step 6
Any abnormalities of appearance are reported in the morphology section of the report. For WBCs, abnormal morphologic features that would be noted include changes in overall cellular appearance, such as cytoplasmic toxic granulation and nuclear abnormalities such as hypersegmentation. The clinical significance of these types of changes is discussed in Chapter 29.
To summarize the WBC parameters, begin with an accurate total WBC count, followed by the relative differential, or preferably the absolute counts, noting whether any abnormal young cells are present in the blood. Finally, note the presence of any abnormal morphology or inclusions.
Summarizing red blood cell parameters
RBC parameters are as follows:
1. RBC count (RBCs × 1012/L)
2. HGB (g/dL)
3. HCT (% or L/L)
4. Mean cell volume (MCV, fL)
5. Mean cell hemoglobin (MCH, pg)
6. Mean cell hemoglobin concentration (MCHC, g/dL)
7. RBC distribution width (RDW, %)
8. Morphology
Step 1
Examine the hemoglobin (or hematocrit) for anemia or polycythemia. Anemia is the more common condition. If the RBC morphology is relatively normal, three times the hemoglobin approximates the hematocrit; this is called the rule of three (Chapter 14). If the rule of three holds, the expectation is that the following assessments will find normal RBC parameters. If the rule of three fails and all test results are reliable, further assessment should uncover some patient RBC abnormalities. Remember that the rule of three only holds true when overall red blood cell morphology is normocytic and normochromic.
Hemoglobin concentration (HGB) is a more reliable indicator of anemia than is the hematocrit, because the hematocrit can be influenced by the size of the RBCs. Hemoglobin concentration is a more direct indicator of the ability of the blood to carry oxygen.
Step 2
When the hemoglobin and hematocrit values have been inspected and the rule of three applied, the next RBC parameter that should be evaluated is the MCV (Chapter 14). This value provides the average RBC volume. The MCV should be correlated with the RBC histogram from the instrument and morphologic appearance of the cells using the classification first introduced by Wintrobe a century ago (Table 16-3).
TABLE 16-3
Interpretation of Mean Cell Volume Values Using the Wintrobe Terminology
|
Mean Cell Volume Value |
Wintrobe Description |
|
Within reference interval (80–100 fL) |
Normocytic |
|
Lower than reference interval (< 80 fL) |
Microcytic |
|
Higher than reference interval (> 100 fL) |
Macrocytic |
The MCV is expected to be within the established reference interval (approximately 80 to 100 fL), and the RBC histogram and morphology are expected to be normal (normocytic). For a patient with anemia, classifying the anemia morphologically by the MCV narrows the range of possible causes to microcytic, normocytic, or macrocytic anemias (Chapter 19).
Step 3
Examine the MCHC to evaluate how well the cells are filled with hemoglobin. Remember that MCHC is a concentration and takes into consideration the volume of the red blood cells when considering decreased or normal color. If the MCHC is within the reference interval, the cells are considered normal or normochromic and display typical central pallor of one third the volume of the cell. If the MCHC is below the reference interval, the cells are called hypochromic, which literally means “too little color.” This correlates with a larger central pallor (hypochromia) when the cells are examined on a Wright-stained blood film.
It is possible for the MCHC to be elevated in two situations, but this does not correlate with hyperchromia. In fact, the term hyperchromia is never used. A slight elevation may be seen when cells are spherocytic (MCHC over 36 g/dL). They retain roughly normal volume but have decreased surface area. So the hemoglobin is slightly more concentrated than usual, and the cells look darker with no central pallor. A more dramatic increase in MCHC (values even as high as 60) can be caused by analytical problems, often associated with patient sample problems that falsely elevate hemoglobin measurement. Common problems of this type include interference from lipemia, icterus, or grossly elevated WBC counts. Each of these interferes with the spectrophotometric measurement of hemoglobin, thus falsely elevating the hemoglobin and affecting the calculation of the MCHC (Chapter14). It is worth noting that the MCHC is often best used as an internal quality control parameter.
Step 4
The RDW is determined from the histogram of RBC volumes. Briefly, when the volumes of the RBCs are about the same, the histogram is narrow (, Figure 16-13 A). If the volumes are variable (more small cells, more large cells, or both), the histogram becomes wider. The width of the histogram, the RDW, is reflected statistically as a coefficient of variation (CV) or a standard deviation (SD). Most analyzer manufacturers provide a CV and an SD, and the operator can select which to report. Figure 16-13, A-D, depicts RBC histograms demonstrating normal, microcytosis, macrocytosis, anisocytosis, and dimorphic red cell populations.

FIGURE 16-13 Red blood cell histograms. A, Normocytic red blood cell population with MCV of 96.8 fL and RDW(CV) of 14.1%; B, Microcytosis with MCV of 54.6 fL and RDW(CV) of 13.2%; C, Macrocytosis and anisocytosis with MCV of 119.2 fL and RDW(CV) of 23.9%; D, Dimorphic red blood cells with MCV of 80.2 fL and RDW(CV) of 37.2%. Note the microcytic and the normocytic red blood cell populations. Reference intervals: MCV, 80-100 fL; RDW(CV), 11.5%-14.5%. MCV, Mean cell volume;RDW(CV), red blood cell distribution width, coefficient of variation.
Therefore, the RDW provides information about the presence and degree of anisocytosis (variation in RBC volume). What is important is increased values only, not decreased values. If an RDW-CV reference interval is 11.5% to 14.5% and a patient has an RDW-CV of 20.6%, the patient has a more heterogeneous RBC population with more variation in cell volume (anisocytosis). If the RDW is elevated, a notation about anisocytosis is expected in the morphologic evaluation of the blood film. Using the MCV along with the RDW provides the most helpful information (Chapter 19).
Step 5
Examine the morphology for pertinent abnormalities. Whenever anemia is indicated by the RBC parameters reported by the analyzer, and potential abnormal RBC morphology is suggested by the indices and the rule of three, a Wright-stained peripheral blood film must be reviewed. Abnormalities include abnormal volume, abnormal shape, inclusions, immature RBCs, abnormal color, and abnormal arrangement (Chapter 19). The blood film also serves as quality control, because the morphologic characteristics seen through the microscope (e.g., microcytosis, anisocytosis) should be congruent with the results provided by the analyzer. When they do not agree, further investigation is necessary.
If everything in the morphology is normal, by convention, no notation regarding morphology is included. Therefore, any notation in the morphology section requires scrutiny. All RBC-related abnormal morphologic findings should be noted, including specific poikilocytosis (abnormal shape) and the presence of RBC inclusions, such as Howell-Jolly bodies. One of the major challenges is in determining when the amount or degree of an abnormality is worth noting at all (i.e., when it should be reported). Laboratories strive for standardization of reporting. All laboratories must have good standardized morphology criteria and competent staff whose evaluations are consistent with one another and with the standardized criteria used in that facility. Generally a semiquantitative method is used that employs terms such as slight, moderate, and marked or the numbers 1+, 2+, and 3+. Numerical ranges representing the reporting unit are defined; for example, three to six spherocytes per oil immersion field might be reported as 2+ spherocytes. Although this practice has been followed for many years, this semiquantitative method may not best serve the needs of medical staff, and many laboratories are moving toward simplifying their reports to state present for morphologic abnormalities.
The presence of immature RBCs suggests that the bone marrow is attempting to respond to an anemia. Polychromasia on the peripheral blood film indicates bone marrow response. This is manifested by the bluer color of reticulocytes that have entered the bloodstream earlier than usual in the body’s attempt to improve oxygen-carrying capacity. If the anemia is severe, NRBCs also may be present. As noted earlier, it is also important to recognize NRBCs because they may falsely elevate the WBC count and may be an indication of an underlying disease process.
A better way to assess replacement erythropoiesis is with the reticulocyte count and subsequent calculation of the reticulocyte production index, if appropriate. The reticulocyte count is not normally part of the CBC, although it is now performed on the same analyzers. If the reticulocyte count is available with the CBC, its interpretation can improve the assessment of young RBCs (Chapter14).
Step 6
Examine the RBC count and MCH. On a practical level, the RBC count is not the parameter used to judge anemia, because there are some types of anemia, such as the thalassemias (Chapter 28), in which the RBC count is normal or even elevated. Thus the assessment of anemia would be missed by relying only on the RBC count. However, this inconsistency (low hemoglobin and high RBC count) is often helpful diagnostically.
The MCH follows the MCV; that is, smaller cells necessarily hold less hemoglobin, whereas larger cells can hold more. For this reason it is less often used than the MCV and MCHC. In the instances in which the MCH does not follow the MCV, the MCHC detects the discrepancy between size and hemoglobin content of the cell. The MCH is not crucial to the assessment of anemia when the other parameters are provided. In summary, when evaluating the RBC parameters of the CBC, examine the hemoglobin first, then the MCV, RDW, and MCHC. Finally, take note of any abnormal morphology.
Summarizing platelet parameters
The platelet parameters of the CBC are as follows:
1. Platelet count (platelets × 109/L)
2. Mean platelet volume (MPV, fL)
3. Morphology
Step 1
The platelet count should be examined for increases (thrombocytosis) or decreases (thrombocytopenia) outside the established reference interval. A patient who has unexplained bruising or bleeding may have a decreased platelet count. The platelet count should be assessed along with the WBC count and hemoglobin to determine whether all three are decreased (pancytopenia) or increased (pancytosis). Pancytopenia is clinically significant because it can indicate a possible developing acute leukemia (Chapter 35) or aplastic anemia (Chapter 22). Pancytosis frequently is associated with a diagnosis of polycythemia vera (Chapter 33).
Step 2
Compare the instrument-generated MPV with the MPV reference interval, 6.9 to 10.2 fL, and with the platelet diameter observed on the peripheral blood film. An elevated MPV should correspond with increased platelet diameter, just as an elevated MCV reflects macrocytosis. In platelet consumption disorders such as immune thrombocytopenic purpura, an elevated MPV, accompanied by platelets 6 μm or larger in diameter (giant platelets), reflects bone marrow release of early “stress” or “reticulated” platelets, evidence for bone marrow compensation (Chapter13 and Figure 13-9).10, 11 Comparing platelet diameter by visual inspection with MPV is a recommended quality control step; however, the MPV has a wide percent CV, which reflects interindividual variation and platelet swelling in EDTA and reduces its clinical effectiveness.12Some instruments identify and record a reticulated platelet count using nucleic acid dye, analogous to a reticulocyte count. Figure 16-14 demonstrates platelet histograms with a normal platelet population (A) and one with giant platelets (B).

FIGURE 16-14 Platelet histograms. A, Normal with MPV of 8.0 fL; B, Platelet population with abnormal histogram and MPV of 9.1 fL. Although the MPV is within the reference interval, the histogram shows an increase in the number of platelets with a volume between 10 and 20 fL (curve above baseline) representing giant platelets. Reference interval for MPV: 6.8-10.2 fL. MPV, Mean platelet volume.
Step 3
Examine platelet morphology and platelet arrangement. Although the MPV can recognize abnormally large platelets, the morphologic evaluation also notes this. Some laboratories distinguish between large platelets (two times normal size) and giant platelets (more than twice as large as normal) or compare platelet size to RBC size.
Additional morphologic descriptors include terms for reporting granularity, which is most important if missing, and in this case the platelets are described as “hypogranular” or “agranular.” Sometimes the abnormalities are too variable to classify, and the platelets are described simply as “bizarre” or dysplastic. In some cases, platelets can be clumped or adherent to WBCs, and these arrangements should be noted. As described previously, corrective actions can be taken to derive accurate platelet and WBC counts when these arrangements are observed on the film. Summarizing platelet parameters includes reporting total number, platelet size by either instrument MPV or morphologic evaluation, and platelet appearance.
gives an example of how the entire CBC can be summarized using the steps described. When results of the CBC are properly summarized and no information has been overlooked, there is confidence that the phase 2 interpretation of the results will be reliable. Adopting a methodical approach to examining each parameter ensures that the myriad information available from the CBC can be used effectively and efficiently in patient care. Box 16-8Box 16-9 summarizes the systematic approach to CBC interpretation.
BOX 16-8
Applying a Systematic Approach to Complete Blood Count Summarization
A specimen from an adult male patient yields the following CBC results (refer to the reference intervals inside the front cover of this book):
WBCs—3.20 × 109/L
RBCs—2.10 × 1012/L
HGB—8.5 g/dL
HCT—26.3%
MCV—125 fL
MCH—40.5 pg
MCHC—32.3 g/dL
RDW—20.6%
PLT—115 × 109/L
Differential in percentages:
Neutrophils—43
Bands—2
Lymphocytes—45
Monocytes—10
Morphology: hypersegmentation of neutrophils, anisocytosis, macrocytes, oval macrocytes, occasional teardrop, Howell-Jolly bodies, and basophilic stippling
The step-by-step assessment of the WBCs indicates that the WBC count is accurate and can be interpreted as leukopenia. Although the relative differential values are all within the reference intervals, calculation of absolute counts indicates an absolute neutropenia and lymphopenia. No unexpected young WBCs are noted, but the morphology indicates hypersegmentation of neutrophils. For the RBCs, the hemoglobin concentration (8.5) indicates that this person is anemic. Inspection of the MCV indicates macrocytosis because the MCV is increased to more than 100 fL, the upper limit of the reference interval. Examination of the MCHC shows it to be normal, so for these results, the RBC morphology would be described as macrocytic, normochromic. The elevated RDW indicates substantial anisocytosis. There is no mention of polychromasia, so no young RBCs are seen. The morphologic description supports the interpretation of the RDW with mention of anisocytosis due to macrocytosis and poikilocytosis characterized by oval macrocytes and occasional teardrop cells. Howell-Jolly bodies and basophilic stippling are significant RBC inclusions. The platelet count indicates thrombocytopenia. Although MPV is not reported, the platelets are of normal size and show no morphologic abnormalities because there are no notations in the morphologic descriptions.
CBC, Complete blood count; HCT, hematocrit; HGB, hemoglobin; MCH, mean cell hemoglobin; MCHC, mean cell hemoglobin concentration; MCV, mean cell volume; MPV, mean platelet volume; RBC, red blood cell; RDW, RBC distribution width; WBC, white blood cell.
BOX 16-9
Systematic Approach to Complete Blood Count Interpretation
White blood cells
Step 1: Ensure that the WBC count is accurate. Review WBC histogram and/or scatterplot and correlate with counts. The presence of nucleated RBCs may require correction of the WBC count.
Step 2: Compare the patient’s WBC count with the laboratory’s established reference interval.
Steps 3 and 4: Examine the differential information (relative and absolute) on variations in the distribution of WBCs.
Step 5: Make note of immature cells in any cell line reported in the differential that should not appear in normal peripheral blood.
Step 6: Make note of any morphologic abnormalities and correlate film findings with the numerical values.
Red blood cells
Step 1: Examine the HGB concentration first to assess anemia.
Step 2: Examine the MCV to assess cell volume.
Step 3: Examine the MCHC to assess cell HGB concentration in RBC.
Step 4: Examine the RDW to assess anisocytosis. (Correlate both MCV and RDW with RBC histogram.)
Step 5: Examine the morphologic description and correlate with the numerical values. Look for evidence of a reticulocyte response.
Step 6: Review remaining information.
Platelets
Step 1: Examine the total platelet count.
Step 2: Examine the MPV to assess platelet size.
Step 3: Examine platelet morphology and correlate with the numerical values.
HGB, Hemoglobin; MCHC, mean cell hemoglobin concentration; MCV, mean cell volume; MPV, mean platelet volume; RBC, red blood cell; RDW, RBC distribution width; WBC, white blood cell.
Summary
• Although fewer manual peripheral blood film evaluations are performed today, much valuable information still can be obtained from a well-made and well-stained film.
• The specimen of choice for routine hematology testing is whole blood collected in a lavender/purple topped tube. The tube additive is EDTA, which anticoagulates the blood by chelating plasma calcium.
• Only rarely does EDTA create problems in analyzing certain individuals’ blood. EDTA-induced platelet clumping or satellitosis causes automated analyzers to report falsely decreased platelet counts (pseudothrombocytopenia) and falsely increased WBC counts (pseudoleukocytosis). This problem must be recognized through blood film examinations and the proper course of action followed to produce accurate results.
• Several methods exist for making peripheral blood films; however, the manual wedge film technique is used most frequently.
• Learning to make consistently good blood films takes practice. The basic technique can be modified as needed to accommodate specimens from patients with very high or very low hematocrits.
• The stain used routinely in hematology is Wright or Wright-Giemsa stain. Staining of all cellular elements occurs when the pH-specific buffer is added to the stain already on the slide. Staining reactions depend on the pH of the cellular components.
• Wright staining is done manually, by automated techniques, or by quick stains, depending on the laboratory and the number of slides to be processed.
• Peripheral blood films and bone marrow smears always should be evaluated in a systematic manner, beginning with the 10× objective lens and finishing with the 100× oil immersion objective lens. Leukocyte differential and morphologic evaluation, RBC and platelet morphologic evaluation, and platelet number estimate all are included.
• Use of a systematic approach to CBC interpretation ensures that all valuable information is assessed and nothing is overlooked. The systematic approach to CBC interpretation is summarized in Box 16-9.
Now that you have completed this chapter, go back and read again the case study at the beginning and respond to the questions presented.
Review questions
Answers can be found in the Appendix.
1. A laboratory science student consistently makes wedge-technique blood films that are too long and thin. What change in technique would improve the films?
a. Increasing the downward pressure on the pusher slide
b. Decreasing the acute angle of the pusher slide
c. Placing the drop of blood closer to the center of the slide
d. Increasing the acute angle of the pusher slide
2. When a blood film is viewed through the microscope, the RBCs appear redder than normal, the neutrophils are barely visible, and the eosinophils are bright orange. What is the most likely cause?
a. The slide was overstained.
b. The stain was too alkaline.
c. The buffer was too acidic.
d. The slide was not rinsed adequately.
3. A stained blood film is held up to the light and observed to be bluer than normal. What microscopic abnormality might be expected on this film?
a. Rouleaux
b. Spherocytosis
c. Reactive lymphocytosis
d. Toxic granulation
4. A laboratorian using the 40× objective lens sees the following numbers of WBCs in 10 fields: 8, 4, 7, 5, 4, 7, 8, 6, 4, 6. Which of the following WBC counts most closely correlates with the estimate?
a. 1.5 × 109/L
b. 5.9 × 109/L
c. 11.8 × 109/L
d. 24 × 109/L
5. A blood film for a very anemic patient with an RBC count of 1.25 × 1012/L shows an average of seven platelets per oil immersion field. Which of the following values most closely correlates with the estimate per microliter?
a. 14, 000
b. 44, 000
c. 140, 000
d. 280, 000
6. A blood film for a patient with a normal RBC count has an average of 10 platelets per oil immersion field. Which of the following values best correlates with the estimate per microliter?
a. 20, 000
b. 100, 000
c. 200, 000
d. 400, 000
7. What is the absolute count (× 109/L) for the lymphocytes if the total WBC count is 9.5 × 109/L and there are 37% lymphocytes?
a. 3.5
b. 6.5
c. 13
d. 37
8. Which of the following blood film findings indicates EDTA-induced pseudothrombocytopenia?
a. The platelets are pushed to the feathered end.
b. The platelets are adhering to WBCs.
c. No platelets at all are seen on the film.
d. The slide has a bluish discoloration when examined macroscopically.
9. Which of the following is the best area to review or perform a differential on a stained blood film?
a. Red blood cells are all overlapped in groups of three or more.
b. Red blood cells are mostly separated, with a few overlapping.
c. Red blood cells look flattened, with none touching.
d. Red blood cells are separated and holes appear among the cells.
10. Use the reference intervals provided inside the front cover of this text. Given the following data, summarize the following blood picture:
WBC: 86.3 × 109/L
HGB: 9.7 g/dL
HCT: 24.2%
MCV: 87.8 fL
MCHC: 33.5%
PLT: 106 × 109/L
a. Leukocytosis, normocytic-normochromic anemia, thrombocytopenia
b. Microcytic-hypochromic anemia, thrombocytopenia
c. Neutrophilia, macrocytic anemia, thrombocytosis
d. Leukocytosis, thrombocytopenia
References
1. Kennedy J. B, Maehara K. T, Baker A. M. Cell and platelet stability in disodium and tripotassium EDTA. Am J Med Technol; 1981; 47:89-93.
2. Perkins S. L. Examination of the blood and bone marrow. In: Greer J. P, Foerster J, Rodgers G. M, et al. Wintrobe’s Clinical Hematology. 12th ed. Philadelphia : Wolters Kluwer Health/Lippincott Williams & Wilkins 2009; 1-20.
3. Shahab N, Evans M. L. Platelet satellitism. N Engl J Med; 1998; 338:591.
4. Bartels P. C, Schoorl M, Lombarts A. J. Screening for EDTA-dependent deviations in platelet counts and abnormalities in platelet distribution histograms in pseudothrombocytopenia. Scand J Clin Lab Invest; 1997; 57:629-636.
5. Lombarts A, deKieviet W. Recognition and prevention of pseudothrombocytopenia and concomitant pseudoleukocytosis. Am J Clin Pathol; 1988; 89:634-639.
6. De Caterina M, Fratellanza G, Grimaldi E, et al. Evidence of a cold immunoglobulin M autoantibody against 78 kD platelet gp in a case of EDTA-dependent pseudothrombocytopenia. Am J Clin Pathol; 1993; 99:163-167.
7. Alpha Scientific Corp. Diff-safe blood dispenser. Retrieved from Available at: http://www.alpha-scientific.com/Diff-safe.xhtml Accessed 11.04.14.
8. Power K. T. The Romanowsky stains a review. Am J Med Technol; 1982; 48:519-523.
9. MacGregor R. G, Scott R. W, Loh G. L. The differential leukocyte count. J Pathol Bacteriol; 1940; 51:337-368.
10. Briggs C, Harrison P, Machin S. J. Continuing developments with the automated platelet count. Int J Lab Hematol; 2007; 29:77-91.
11. Abe Y, Wada H, Sakakura M, et al. Usefulness of fully automated measurement of reticulated platelets using whole blood. Clin Appl Thromb Hemost; 2005; 11:263-270.
12. Ryan D. H. Examination of the blood. In: Lichtman M. A, Beutler E, Kipps T. J. Williams Hematology. 8th ed. New York : McGraw-Hill 2011 Ch. 2.
13. Cornbleet P. J. Clinical utility of the band count. Clin Lab Med. Mar; 2002; 22(1):101-136.
14. Clinical and Laboratory Standards Institute. Reference leukocyte (WBC) differential count (proportional) and evaluation of instrumental methods; approved standard. 2nd ed : (H20-A2). Vol 27(4): Clinical and Laboratory Standards Institute (CLSI) 2007.